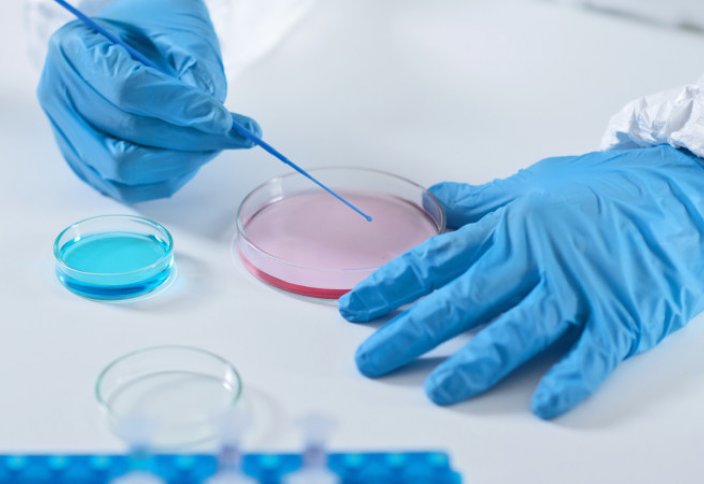
Совет по биологической безопасности появится в Казахстане

|
Совет по биологической безопасности появится в Казахстане
|
Совет по биологической безопасности появится в Казахстане, передает Tengrinews.kz со ссылкой на Акорду.
"Нынешний кризис показал всему миру, насколько важна социальная сфера: медицина, образование, социальная защита. Нам нужны коренные преобразования, направленные на повышение качества систем здравоохранения, полное технологическое переоснащение медицинских учреждений, повышение компетентности медицинского персонала. Адаптационные системы необходимы для быстрого реагирования на чрезвычайные ситуации любого характера", - говорится в тексте заявления Президента страны Касым-Жомарта Токаева.
Отмечается, что должны быть разработаны подходы к демографическому контролю, внедрению телемедицины и дистанционной диагностики.
"Необходимо коренным образом укрепить национальную санитарно-эпидемиологическую службу. По общему мнению, COVID-19 и подобные вирусы не разовое событие. Поэтому нам необходимо быть постоянно готовыми не только с практической, но и с научной точки зрения. Правительство должно сформировать Совет по биологической безопасности с привлечением авторитетных ученых и экспертов", - заявил Президент.













